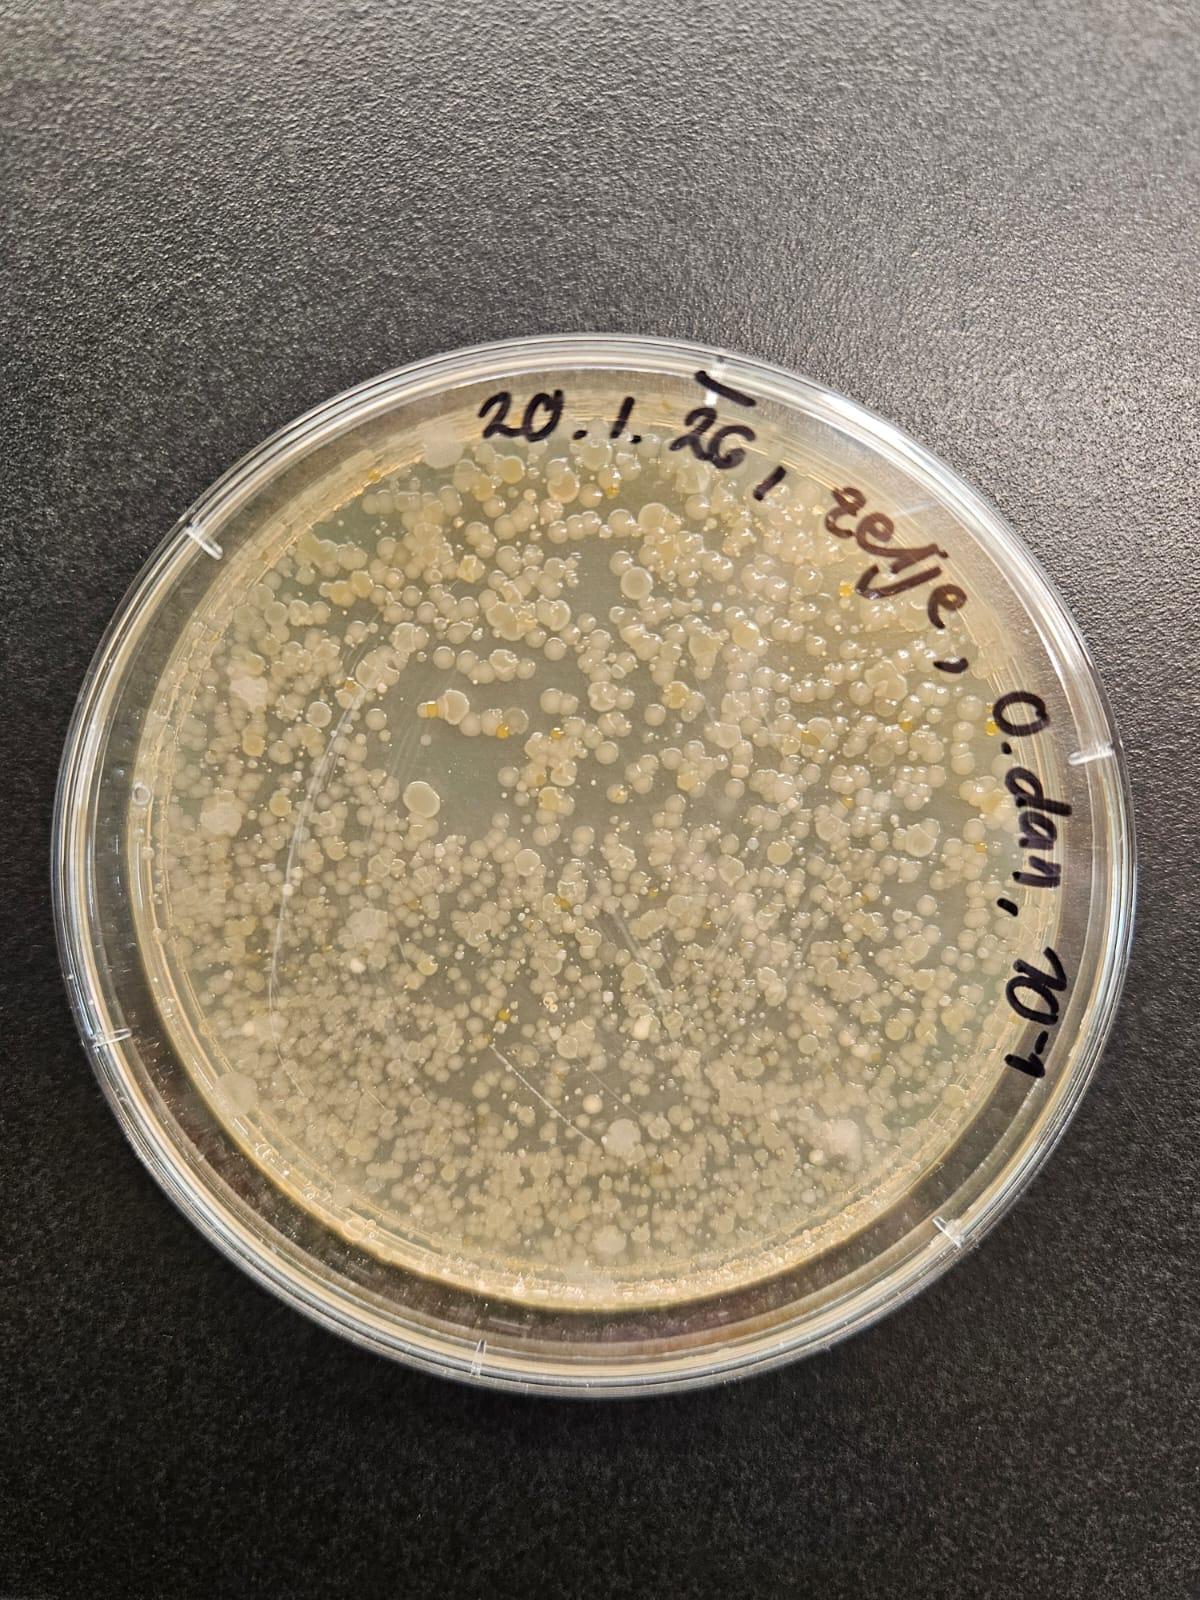
Dan 0 – bakterije
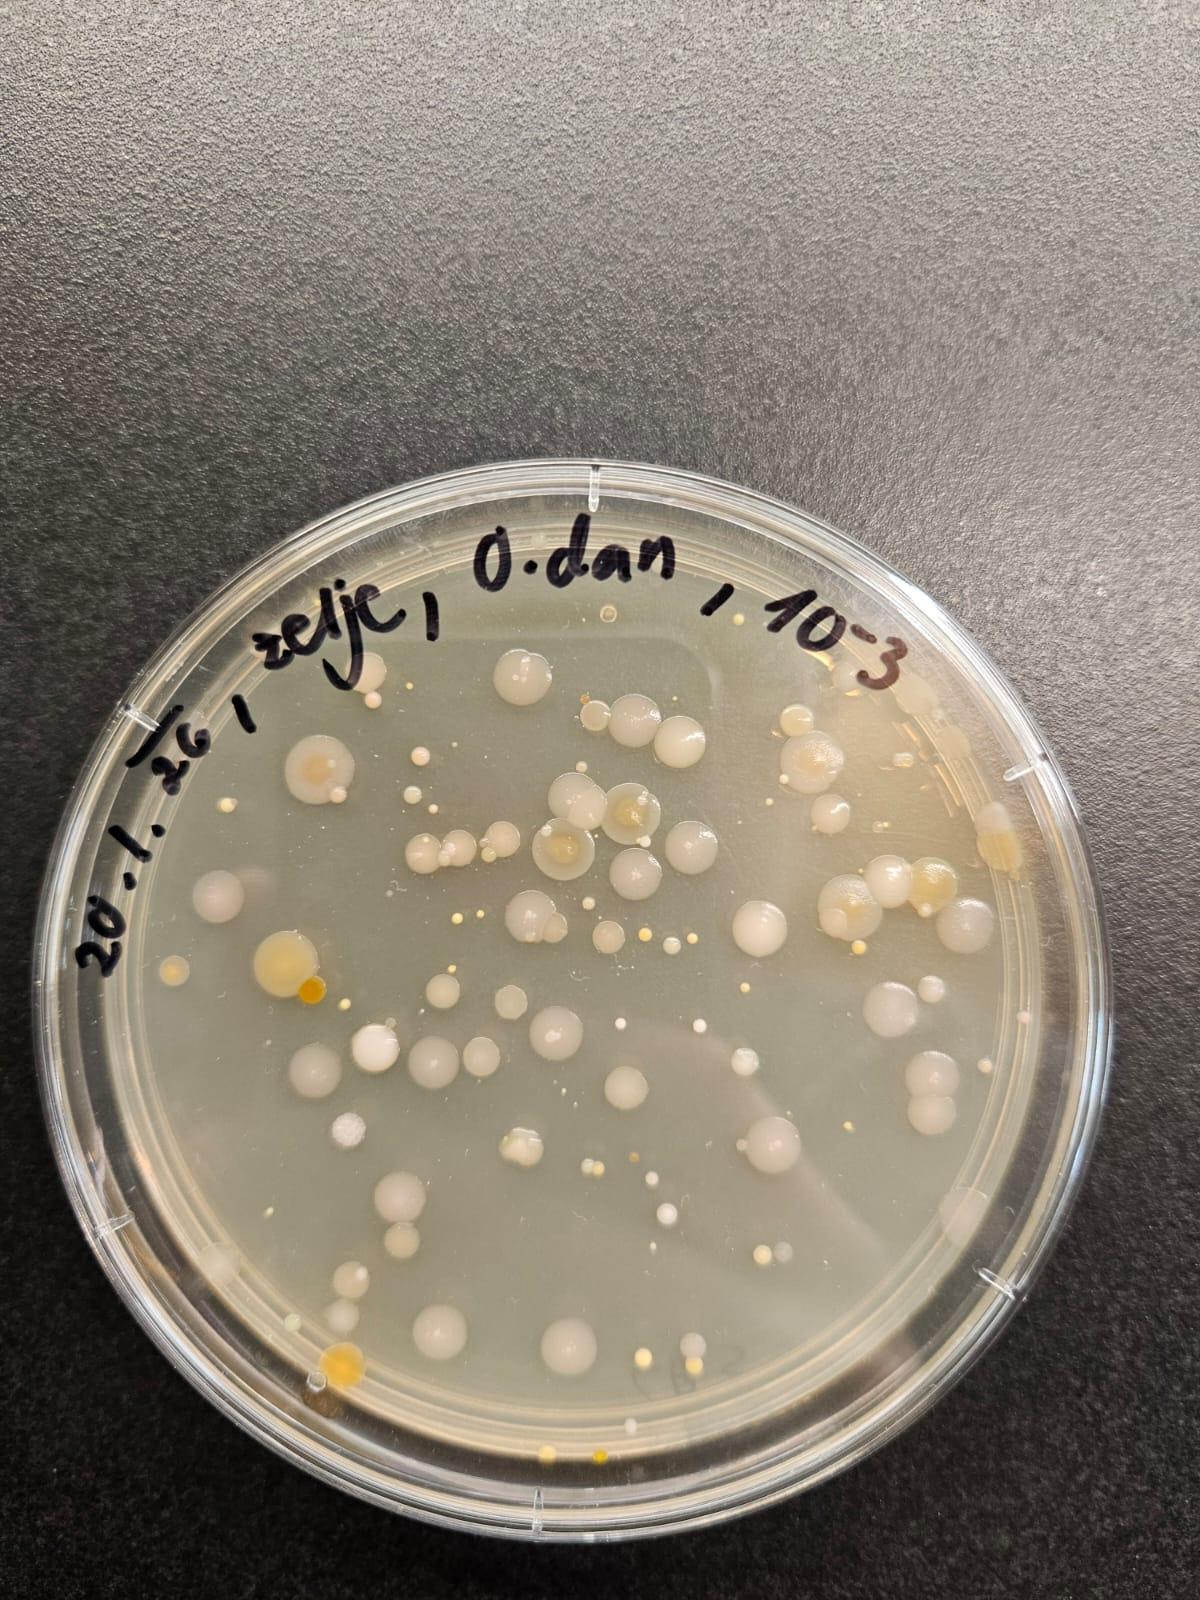
Dan 0 – bakterije
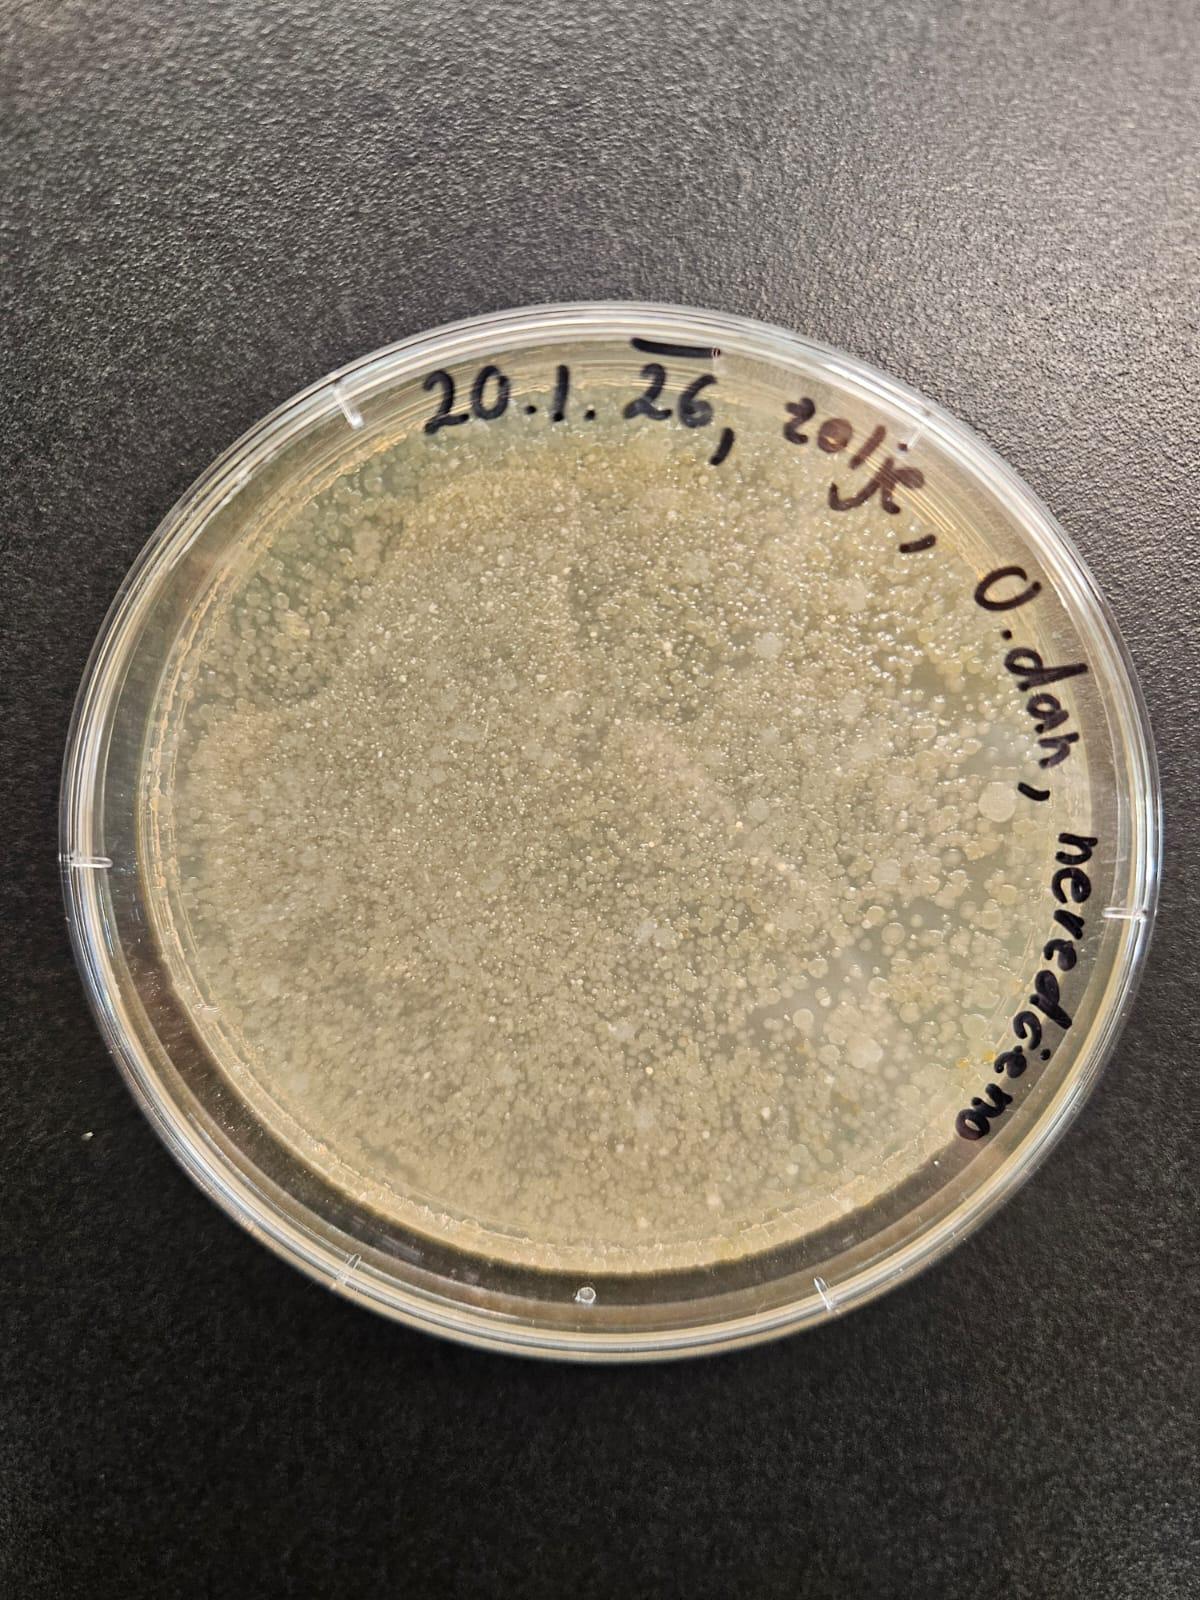
Dan 0 – bakterije
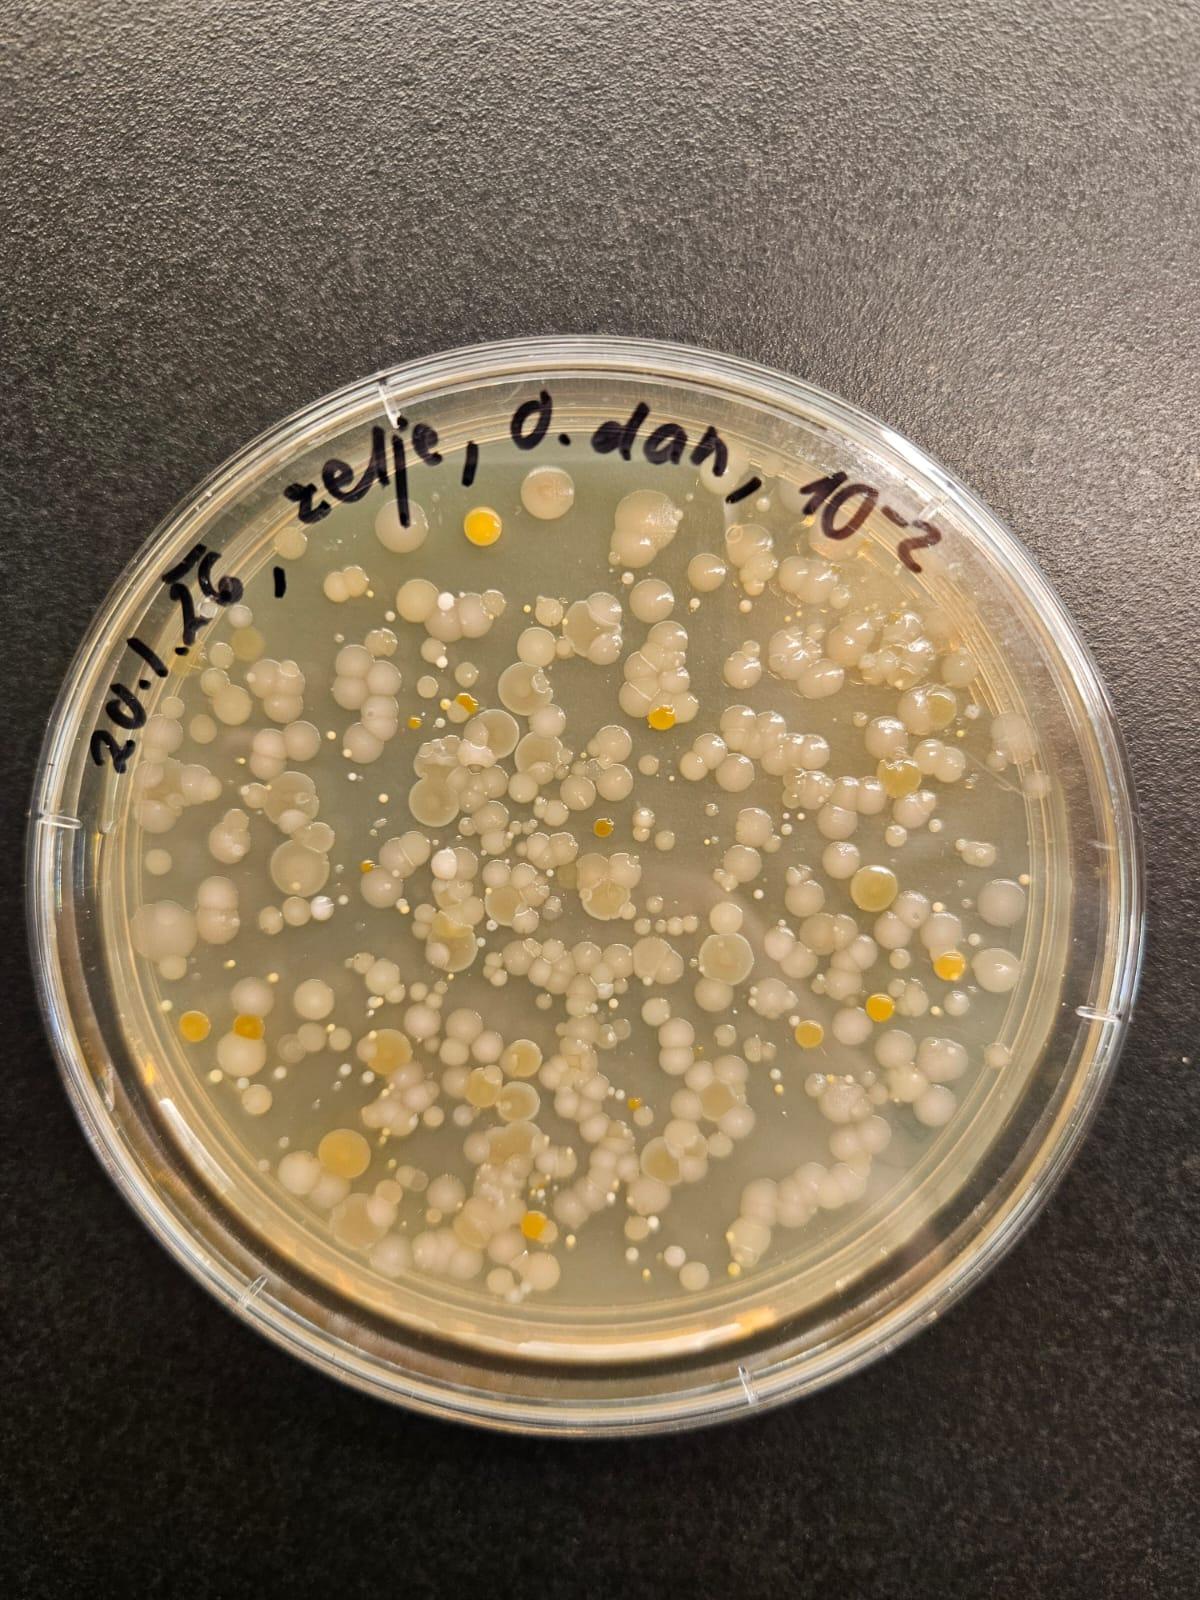
Dan 0 – bakterije
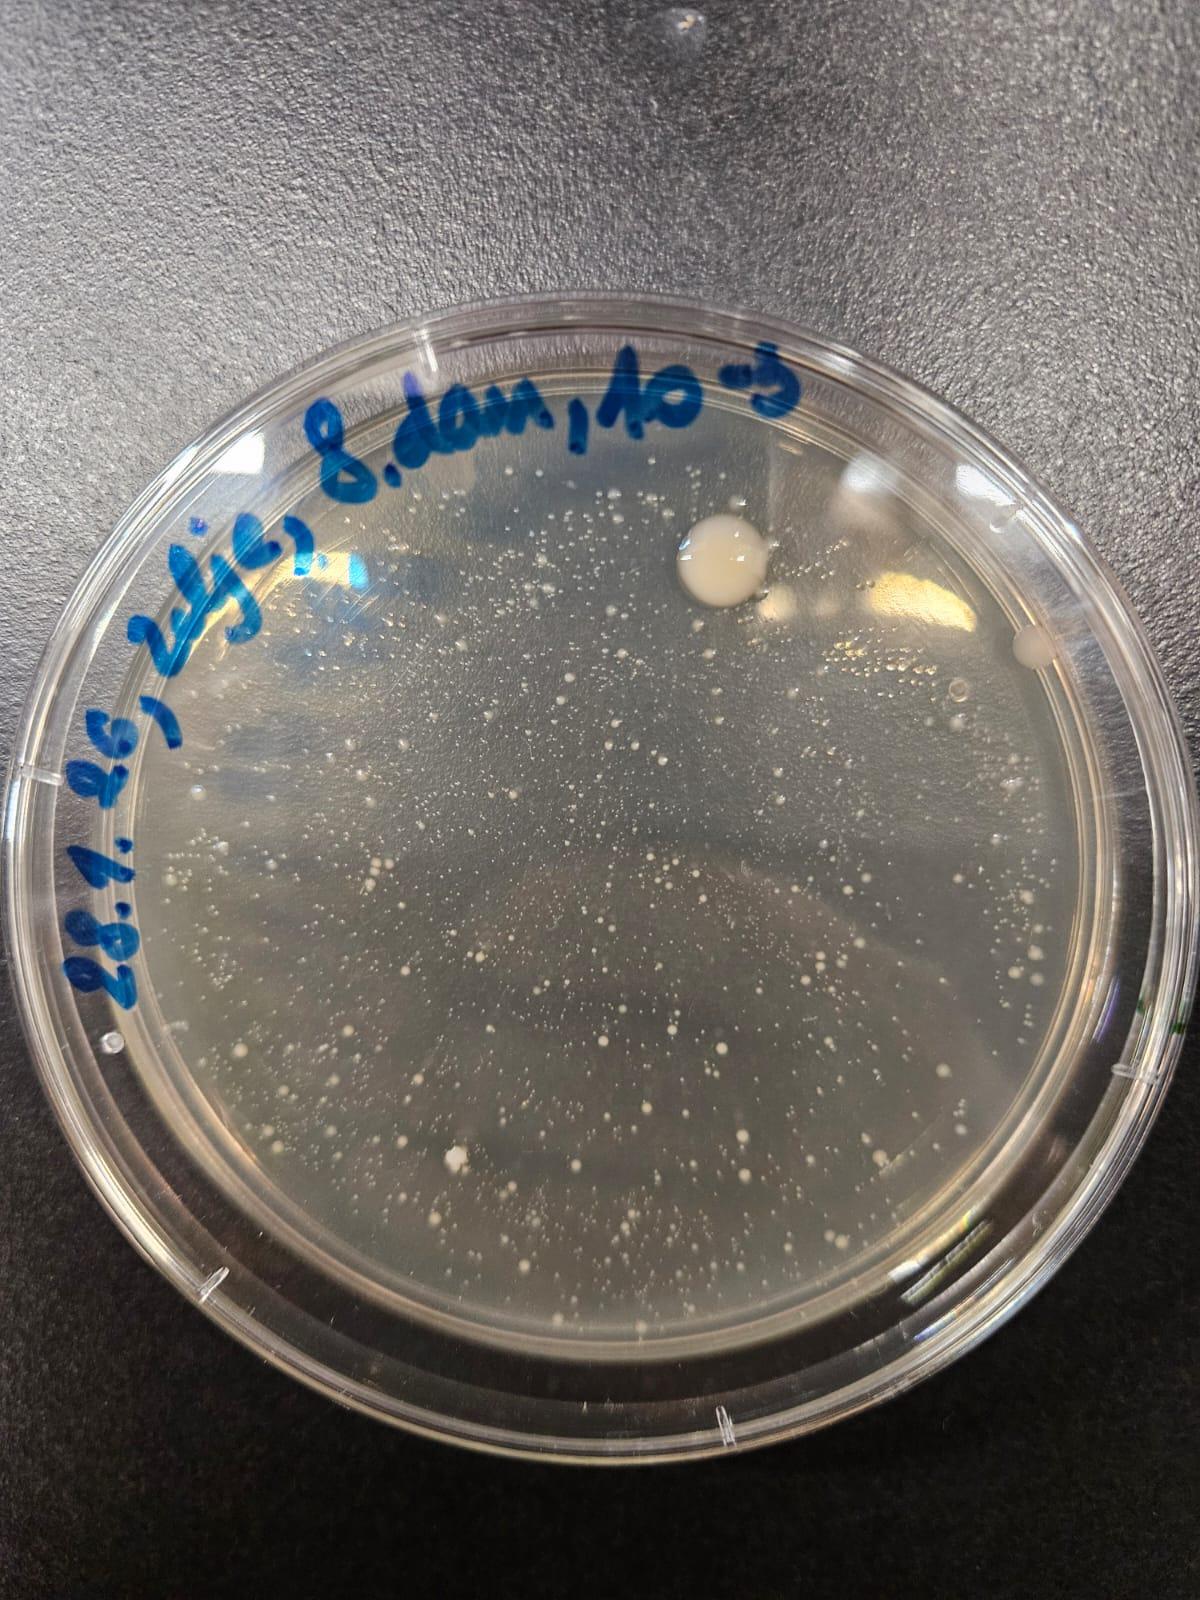
Dan 8 – 100x redčene
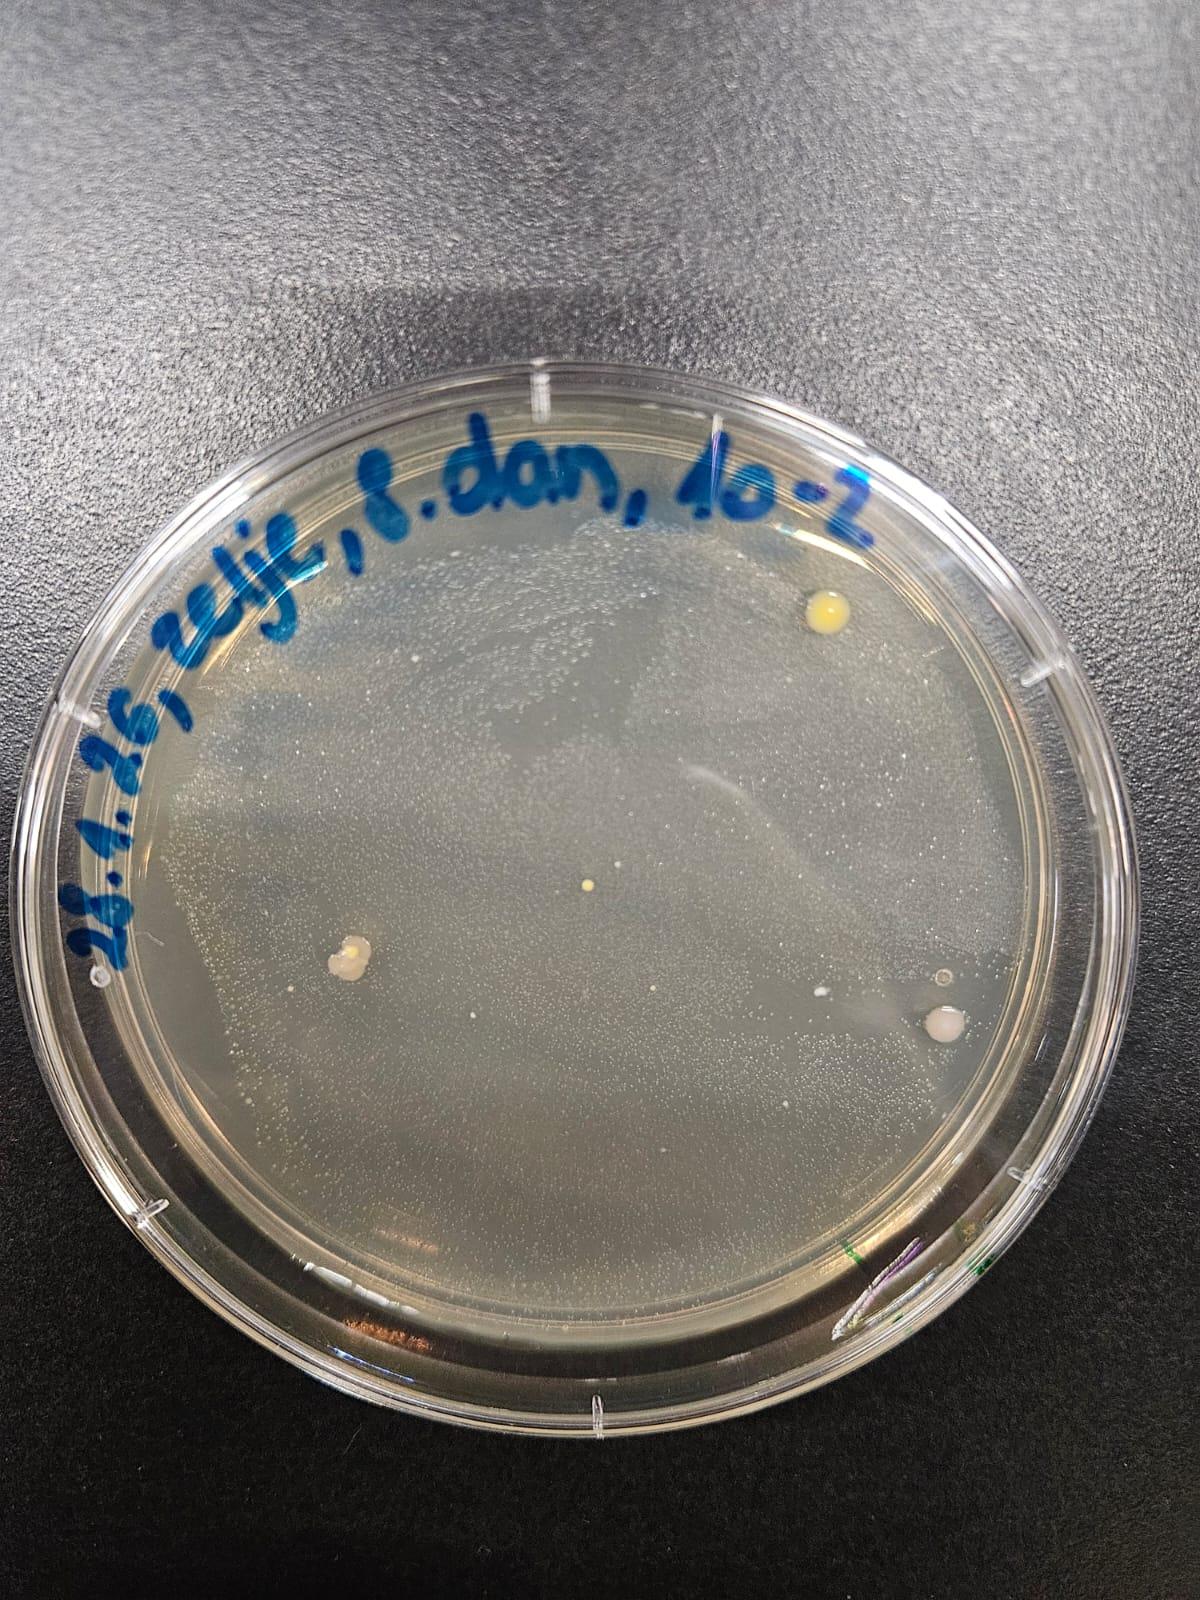
Dan 8 – 1000x redčene
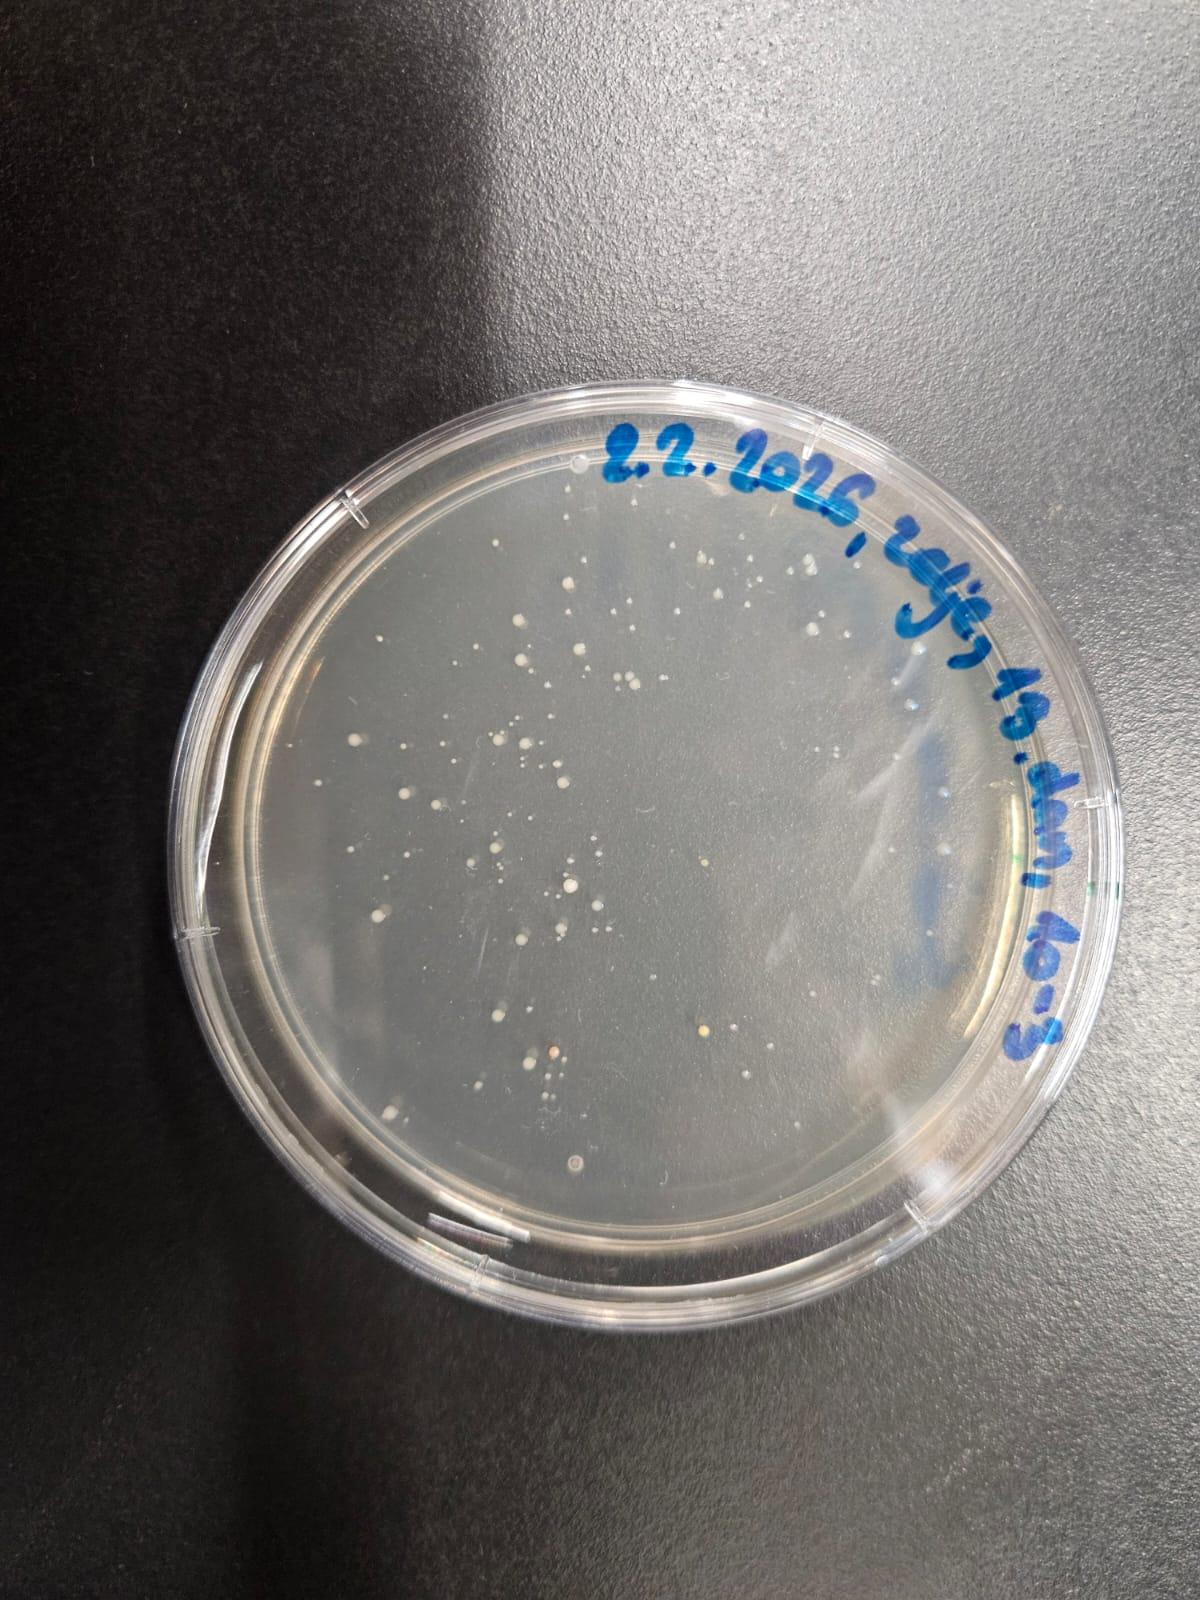
Dan 13 – 100x redčene
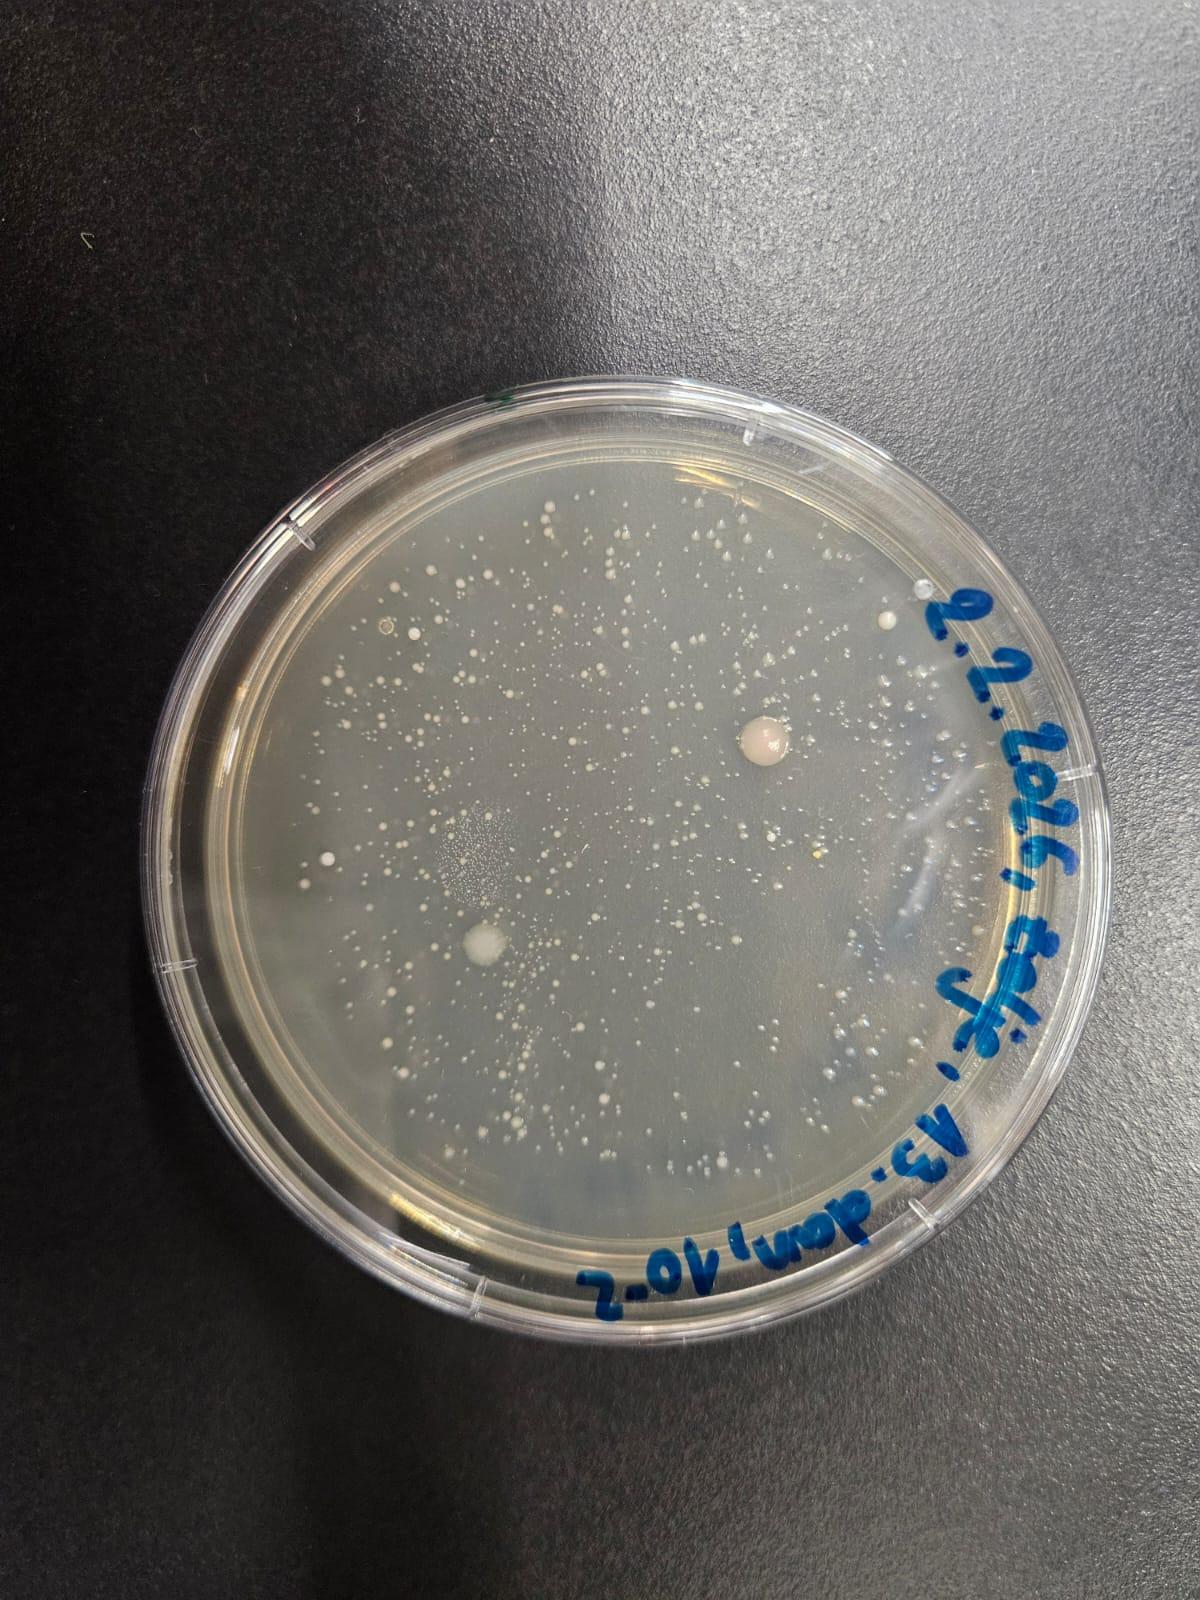
Dan 13 – 1000x redčene

Za kosilo sta bila pečenica in kislo zelje. Sprašujeva pa se, kako kmetje naredijo kislo zelje? Saj mar ne zraste že pripravljeno na drevesu, kajne? No, res ne zraste na drevesu. In pridelava kislega zelja je prava kemija!
Zato sva se odločili, da bova pisali raziskovalno nalogo o kisanju zelja. In ker sva hoteli preveriti, kaj se zares dogaja med fermentacijo, sva začeli s pravim laboratorijskim poskusom.

Kislo zelje v kozarcu, pripravljeno na postrežbo.
Kako nastane kislo zelje?
Zelje je kapusnica in izvira iz Evrope in Azije. Obstaja več vrst fermentacije – med najpogostejšimi sta alkoholna fermentacija (pivo, vino) in mlečnokislinska fermentacija (kislo zelje, jogurt).
Kislo zelje dobi svoj značilen okus zaradi kemične reakcije, imenovane "mlečnokislinska fermentacija". Med kisanjem ogljikovi hidrati v živilih s pomočjo bakterij pretvorijo v mlečno kislino, kar jim podaljša življenjsko dobo in spremeni okus.
Kaj je pH?
pH je mera, s katero merimo kislost oz. bazičnost. Lestvica seže od 0 do 14.
Kaj so bakterije in mikroorganizmi?
Mikroorganizmi so zelo majhna živa bitja – bakterije, nekateri enoceličarji in nekatere glive. Večine ne moremo videti s prostim očesom, ampak jih opazujemo z mikroskopom.
Bakterije so tako majhna bitja, da jih je nemogoče videti s prostim očesom, razen če zrastejo v gojilnici. V kislem okolju večina škodljivih bakterij težje uspeva – zato je kisanje učinkovit način konzerviranja živil.
Nekatere bakterije, kot so lactobacili, uspevajo v kislem okolju in so ključne pri kisanju – saj proizvajajo mlečno kislino.

Bakterije pod mikroskopom
Katere bakterije sodelujejo pri kisanju?
Da se fermentacija zgodi, potrebujemo bakterije. Spodaj so naštete vse, ki sodelujejo pri kisanju zelja:
- Leuconostoc mesenteroides
- Lactobacillus plantarum
- Lactobacillus brevis
- Pediococcus pentosaceus
- Lactobacillus cucumeris
Zakaj so fermentirana živila koristna?
Fermentirana živila so koristna, ker se jih lahko shrani za dolgo časa, ne da bi se pokvarila. Zato so jih v starih časih imeli za ozimnico.
Nekatera kisana živila so tudi lažje prebavljiva in vsebujejo probiotike – koristne bakterije za naše črevesje.

Fermentirana živila
Cel proces kisanja zelja traja 16–20 dni. Vzorce zeljenega soka sva jemali na dan 0, 8, 13 in 18 ter jih v petrijevi posodici pustili rasti 5 dni pri sobni temperaturi. Vsaka pikica predstavlja eno kolonijo bakterij.
Priprava zelja
Zelje sva naribali (≈30 min za eno glavo) in tlačili z 2% soli (≈45 min), dokler ni iztisnilo skoraj vse vode. Zelje sva dajali v plasti po 4 cm, potlačili na 1–2 cm, dodali sol in ponavljali, dokler zelje ni bilo potopljeno pod vodo. Sol preprečuje rast škodljivih bakterij.
0
Dan 0 – Začetek kisanja
Takoj na začetku je prisotnih ~10 različnih vrst bakterij (vidimo jih po obliki in velikosti pikic). Kolonije se razlikujejo po izgledu, barvi, obliki in velikosti.

Bakterije neredčene, 10x, 100x in 1000x redčene – Dan 0


Bakterije v petrijevi posodici – Dan 0
8
Dan 8 – Fermentacija v teku
Po 8 dneh smo nanesli vzorec drugič. Število bakterij se je povečalo, število različnih vrst pa se je zmanjšalo – vidimo le še ~5 različnih vrst. Sol in mlečna kislina sta začeli odpravljati škodljive bakterije.

Bakterije 100x in 1000x redčene – Dan 8
13
Dan 13 – Napredek kisanja
Na 13. dan smo nanesli vzorec tretjič. Fermentacija napreduje – pH pada, mlečnokislinske bakterije prevladujejo.

Bakterije 100x in 1000x redčene – Dan 13
18
Dan 18 – Kislo zelje pripravljeno!
Po 18 dneh je prisotnih le še ~2 vrsti bakterij (večinoma Lactobacillus). Vse je potekalo tako, kot sva želeli.
Sol je preprečila rast škodljivih mikroorganizmov, slan zeljni sok pa je ustvaril ugodno okolje za mlečnokislinske bakterije, ki so zaščitile zelje pred plesnimi in škodljivci.

Ta zeljna glava bo kmalu postala kislo zelje
Kisanje zelja nekoč in danes
Izbrali so lepe glave, jih naribali, dali v velike lesene posode ali kadi v kleti in pokrili ter obtežili s kamni. Tam so jih za nekaj časa pustili in kislo zelje je bilo narejeno.
Večina ljudi zelje kupuje v trgovini, kjer je že pripravljeno. Vendar nekateri (predvsem kmetje) še vedno ohranjajo tradicijo in zelje kisajo doma.
Pomagali so nama:
In seveda midve, ki sva naredili večino dela!